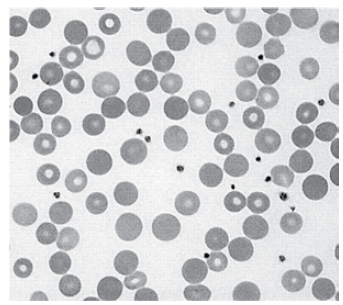
Enunciado 3636499-1

Homem de 32 anos é avaliado por causa de uma anemia que teve ao longo da vida. A história médica pregressa é significativa para colecistectomia devido a cálculos biliares, realizada 3 anos antes. Refere que um primo em primeiro grau também fez uma colecistectomia em idade jovem. Ele está bem e nega sintomas relevantes. Os exames séricos mostram: hemoglobina: 10,2 g/dL; leucócitos e plaquetas: normais; bilirrubina total: 4,2 mg/dL; bilirrubina direta: 0,3; desidrogenase lática: 620 U/L (normal até 246). O esfregaço de sangue periférico é mostrado a seguir.
O diagnóstico mais provável é